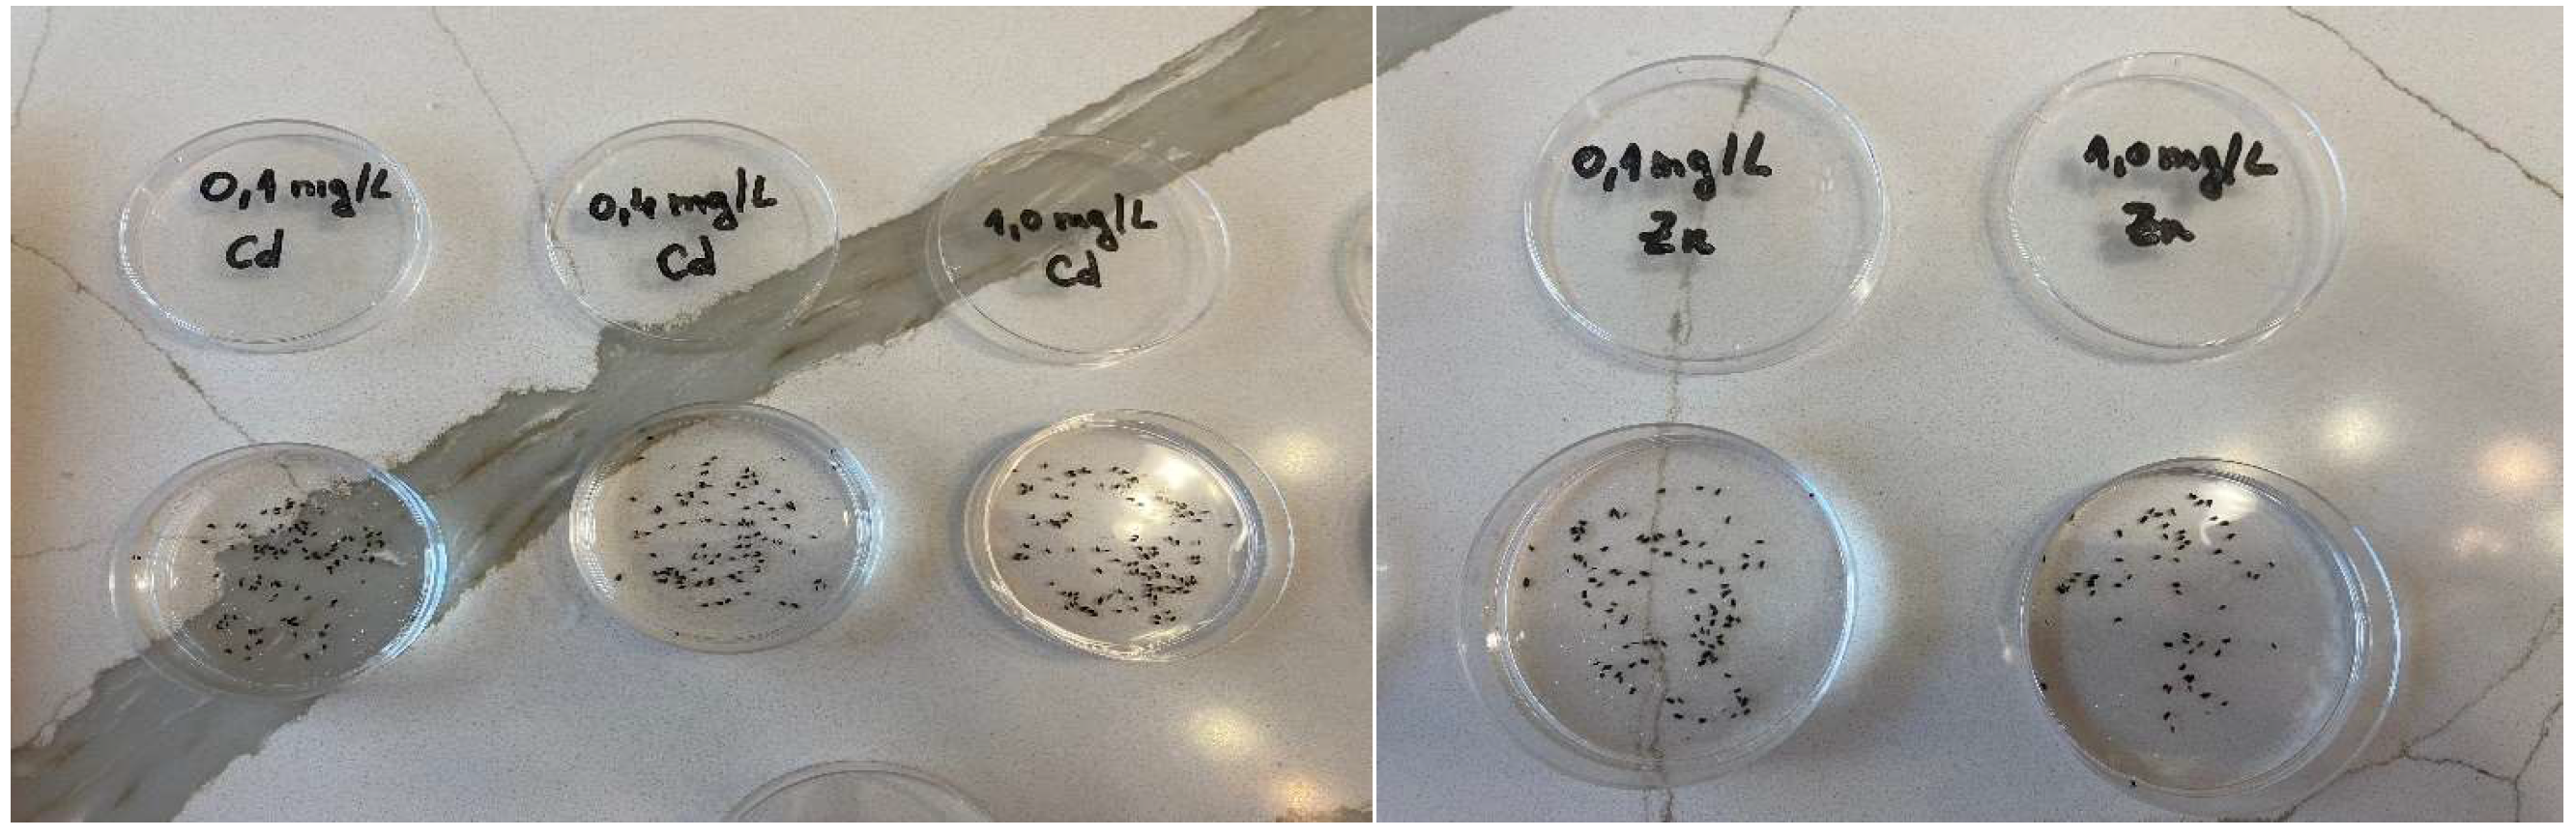
Environments 12 00070 g002

Abstract
This study analyzes the acute toxicity of Zn2+, Cd2+, and Cu2+ on water fleas. The hatching rate of D. magna ephippia was monitored under the influence of the pollutant at concentrations of 0.1 mg/L, 0.2 mg/L, 0.3 mg/L, 0.4 mg/L, 0.5 mg/L, and 1.0 mg/L over an exposure period of 42 h−67 h. The mortality rate of newborns was determined comparing with the control sample at 12 h, 24 h, and 48 h, as well as with the lethal concentration 50% (LC50). The results showed that Zn2+ appears to be less toxic to D. magna compared to Cd2+ and Cu2+, even at high concentrations, suggesting a greater tolerance of the ephippia to this metal. Newborn mortality increased significantly with higher concentrations and longer exposure times, with Cd2+ causing mortality rates of up to 100% after 48 h. In contrast, Zn2+ exhibited lower toxicity, although mortality increased with high concentrations and extended exposure periods.
1. Introduction
Daphnia magna, or the water flea, is a small freshwater crustacean. Although they are tolerant organisms, they do not thrive in extreme environments, living in water conditions with a pH range of 6.5 to 9.5 but unable to survive in saline waters. They prefer temperatures between 18 and 22 °C [1].
Daphnia magna is a classic example of a heterogonic life cycle, which alternates between asexual (parthenogenetic) and sexual reproduction depending on environmental conditions. Under favorable conditions (optimal temperature, sufficient food), D. magna reproduces asexually through cyclical parthenogenesis. Females produce diploid eggs (without fertilization), which develop directly into female clones. These eggs hatch quickly, and the offspring are genetically identical to the mother. A full development cycle can take only a few days, leading to rapid population growth.
If resources become scarce or environmental conditions deteriorate (e.g., lack of food, low temperatures, desiccation), sexually reproducing females appear in the population. These females produce haploid eggs that require fertilization. After fertilization, the eggs become resting eggs (latent or ephippial eggs), protected by a shell called the ephippium. Resting eggs can remain viable for months or even years, hatching only when conditions become favorable again [1,2].
These water fleas consume algae, bacteria, and detritus from the water, thus contributing to cleaner water, especially in ponds and lakes. Daphnia can efficiently filter fine particles from the water, reducing turbidity and contributing to its clarification. By consuming algae, Daphnia can help prevent and control harmful algal blooms, which can deteriorate water quality and affect other aquatic life forms. Recent studies have demonstrated that Daphnia can be used as a model organism for monitoring heavy metal pollution. For example, researchers have developed transgenic lines of D. magna that express green fluorescent protein (GFP) in the presence of heavy metals, facilitating the rapid and sensitive detection of contaminants such as zinc, copper, and cadmium [3].
They are also indicator organisms for water quality and are used in water toxicity tests and in the detection of various pollutants [1,4,5,6].
Thus, water fleas are used to analyze ecosystem changes, as they act as a bioindicator model organism in ecotoxicology [7]. In laboratories, they are used due to their ease of cultivation, short life cycle, rapid reproduction, and sensitivity to multiple compounds [8].
Daphnia magna have been used in various studies to assess the toxicity of photocatalytically treated water contaminated with pharmaceutical products [9]. They have also been used to determine the toxicity of duloxetine and econazole mixtures based on exposure time [10]. Another study analyzed their short-term sensitivity by exposing them to 15 different chemical compounds [11].
A separate study examined the toxicity of gemfibrozil on water fleas. In this case, exposure to gemfibrozil had beneficial effects, increasing lipid reserves, body length, and mass, as well as enhancing reproduction [12].
The acute toxicity of inorganic chloramines has also been analyzed [13], along with a range of household products such as toilet cleaner, glass cleaner, hand soap, shampoo, refined oil, and diatomaceous earth [7], polycyclic aromatic hydrocarbons [14], pesticides and insecticides [15], as well as fungicides [16].
The disruption of D. magna populations due to thermal water pollution [17] and exposure to UV radiation [18] has also been investigated.
Zaldívar et al. (2011) [19] highlighted the advantages of a dynamic model for assessing acute or long-term toxicity, considering the inherent variability of D. magna populations and multiple data sources.
Regarding the presence of heavy metals in water, particularly the ones studied, their concentrations have steadily increased due to agrochemical use, industrial waste emissions, mining activities, wastewater treatment, pulp and paper production, and metal processing [20,21,22,23].
Copper is an essential micronutrient for aquatic organisms; however, at high concentrations, it can lead to acute toxicity through bioconcentration processes, causing oxidative stress [24,25,26,27]. It is an omnipresent aquatic contaminant, with surface water concentrations occasionally exceeding 200 μg/L [10]. Water fleas are among the most sensitive organisms to copper, with acute toxicity thresholds as low as 8.4 μg/L and chronic toxicity at 20.2 μg/L [28].
Cadmium can endanger the growth and development of aquatic life. For example, cadmium can inhibit bacterial bioluminescence [29], cause limited activity or even death in Daphnia [30,31] and induce oxidative stress in fish [32].
Regarding the exposure of water fleas to zinc, previous studies have shown that this metal affects body length, induces oxidative stress, reduces energy reserves in D. magna [33], and negatively impacts their reproduction [34].
Aquatic organisms are exposed to multiple stress factors, with temperature and pH being the most significant. These factors influence metal toxicity in aquatic organisms, affecting accumulation kinetics, bioavailability, metabolism, and sensitivity to metals [35,36,37]. All these effects also depend on the age of the studied water fleas [33].
The objective of our research was to evaluate the acute toxicity of cadmium, copper, and zinc on the species D. magna, examining both the effect of these pollutants at various concentrations on ephippial hatching rates and the degree of toxicity and mortality induced in newborn individuals.
2. Materials and Methods
2.1. Preparation of Freshwater Solutions
In one liter of distilled water, 12 mL of the following test solutions were added: NaHCO3 at a concentration of 64.75 mg/L, CaCl2·2 H2O at 294 mg/L, MgSO4·7 H2O at 123.25 mg/L, and KCl at 5.75 mg/L. The mixture was then brought to a final volume of 2000 mL with distilled water and homogenized. The preparation followed the Standard Procedure set by the OECD (Organization for Economic Cooperation and Development, OECD, 2004) [38]. These substances were purchased from MicroBioTests Inc., Belgium, and are part of the Daphtoxkit F kit. The batch number of the test substances is ISOD040123.
2.2. Daphnia Magna Ephippia
The eggs (ephippia) of D. magna are protected by a chitinous capsule called the ephippium and were delivered in 1 mL plastic tubes covered with aluminum foil by MicroBioTests Inc. These were stored in a refrigerator at 5 °C until use.
2.3. Pollutant Solutions Used
The heavy metals used in the preparation of the solutions were cadmium, zinc, and copper, with the following concentrations: Cd (NO3)2 with a concentration of NO3)2 at 104.9505 mg/L, CuSO4 at 111.2567 mg/L, and ZnSO4 at 104.5184 mg/L. Dilutions were made from these stock solutions to obtain the concentrations used in the experiments.
2.4. Experimental Procedure
The study was conducted in two main directions: first, the hatching rate of D. magna ephippia was monitored under the influence of the three studied pollutants at different concentrations; second, the effects of these pollutants, including their acute toxicity and lethality, were evaluated on neonates.
2.4.1. Hatching of Ephippia
Before use, the freshwater solution was aerated for at least 15 min. Dilutions were then prepared using the freshwater solution and the pollutant solutions, resulting in the following experimental concentrations: 0.1 mg/L, 0.2 mg/L, 0.3 mg/L, 0.4 mg/L, 0.5 mg/L, and 1.0 mg/L.
A total of 10 mL of polluted freshwater was transferred to a Petri dish. The contents of the ephippia tube were rinsed with tap water and filtered to remove any traces of the storage medium. After placing the lid on the Petri dish, it was incubated at 22 °C under continuous light. The hatching rate was monitored every 5 h under exposure to the pollutant. Each experimental treatment was replicated four times.
2.4.2. Acute Toxicity of Heavy Metals
After washing, the ephippia were placed in a Petri dish containing clean, unpolluted freshwater. They were then incubated under the same conditions. After incubation, the newly hatched neonates were fed with spirulina, and, after 2 h, groups of 10 neonates were transferred into test wells. Each test well contained 10 mL of pollutant solution and 10 neonates. The concentrations used were the same as those in the hatching study under pollutant exposure.
Parafilm strips were placed over the test plates to minimize solution evaporation during the incubation period. A transparent lid was placed over the plates, and incubation was conducted in darkness at 22 °C. Each experimental condition, including the unpolluted control group, was performed in four replicates. Figure 1 illustrates the experimental procedures carried out.
Figure 1.
Experimental Steps.
2.4.3. Determination of Lethal Concentration 50% (LC50)
Using the LC50 calculator from AAT Bioquest, we entered the concentrations (X values) and the responses expressed as the percentage of mortality in the population (Y values) to obtain the equations necessary for calculating the LC50 value for each pollutant at 12 h, 24 h, and 48 h intervals. The equations followed the general form of
2.5. Analysis of Experimental Data
The newly hatched D. magna neonates were counted between 42 and 67 h after exposure to heavy metal concentrations, and the hatching rate was determined based on the mean value of the replicates and standard deviation.
In the second part of the study, the number of dead individuals—defined as immobile organisms without appendage movement—was recorded at 12, 24, and 48 h of exposure. The acute toxicity EC50 (effective concentration for 50% mortality) was then calculated, along with the mortality rate compared to the control group. Excel was used for data interpretation and graphical representation.
3. Results and Discussion
3.1. Influence of Pollutants on Daphnia Magna Ephippia
After 42 h of incubation in polluted freshwater with different metal concentrations, the first neonates began to emerge. Figure 2 shows some of the experimental conditions used.
Figure 2.
Petri dishes with Daphnia magna ephippia and the pollutant concentrations used in the experiment.
The hatching rate of D. magna ephippia is summarized in Table 1. The maximum observation period for hatching under the influence of heavy metals was 67 h.
Table 1.
Hatching rate of Daphnia magna ephippia.
In the case of freshwater pollution with cadmium, an increase in the hatching rate was observed over time. The same trend was noticed for copper pollution. However, among these two pollutants, cadmium proved to be much more toxic to the ephippia, even at the lowest applied concentration (0.1 mg/L), with a difference of 56% in cadmium-polluted water compared to 82% in copper-polluted water.
Zinc, on the other hand, stimulated hatching, with the rate being significantly higher even after 42 h, reaching over 80–90%.
As the pollutant concentration increased (with a maximum concentration of 1.0 mg/L), the hatching rate decreased by 14% (at 42 h) and 41% (at 67 h) for Cd, 18% (42 h) and 25% (67 h) for Cu, and only 4% (42 h) for Zn, compared to the lowest applied pollutant concentration. Zinc does not negatively affect the ephippia, as its increased concentration had only a minimal impact on their hatching.
According to Table 1, zinc has the least negative effect on ephippia hatching, followed by copper and cadmium. These results are supported by other research data that highlight the long-term negative effects and cumulative impact of heavy metals. Barata C. et al. (2002) [39] investigated the demographic responses of a tropical cladoceran to cadmium exposure, a heavy metal similar to zinc in terms of toxicity. Although their study does not focus exclusively on zinc or D. magna, the results provide insights into how heavy metals can affect reproduction and hatching processes in cladocerans.
3.2. Lethality and Acute Toxicity of Pollutants
Percentage mortality were determined at 12 h, 24 h, and 48 h following exposure of D. magna to concentrations ranging from 0.1 to 1.0 mg/L of Cd2+, Zn2+, and Cu2+. During the exposure period, the water fleas were not fed.
According to the obtained results presented in Figure 3, zinc exhibited the lowest acute toxicity, even after 48 h of exposure. It is well known that zinc has both positive and negative effects on water fleas, depending on its concentration. At low levels, zinc is an essential micronutrient for D. magna, contributing to enzymatic functions and supporting overall health. However, at high concentrations, zinc becomes toxic to water fleas. Prolonged exposure to high doses can impair development and reproduction, and it may even lead to mortality due to excessive metal accumulation, which interferes with normal biological functions such as respiration and cellular metabolism [34].

Figure 3.
Percentage mortality of D. magna under exposure to heavy metals: (a) Cd2+ exposure; (b) Zn2+ exposure; (c) Cu2+ exposure.
The mortality rate recorded in this study due to exposure to the lowest applied zinc concentration (0.1 mg/L) was 0% after 12 h, 33.58% after 24 h, and 69.23% after 48 h compared to the highest applied Zn2+ concentration of 1.0 mg/L, where mortality rates of 10.66% (12 h), 54.13% (24 h), and 90.52% (48 h) were observed. Thus, mortality increased by 69.23% (0.1 mg/L) to 79.86% (1.0 mg/L) over 36 h.
The results obtained regarding the exposure of D. magna to zinc are consistent with those reported by Muyssen et al. (2006) [40], showing a direct relationship between zinc levels and increased mortality, influenced by factors such as zinc concentration in water and exposure duration.
Although Muyssen et al. (2006) [40] did not use the same concentrations of heavy metals, the results indicate the same trend in mortality rates, which are directly proportional to concentration and exposure time.
Cadmium was the most toxic heavy metal for water fleas. Their mortality rate increased by 39.29% within 12 h when exposed to concentrations from 0.1 mg/L to 1.0 mg/L. After 24 h of exposure to Cd2+, the mortality rate ranged from 81.66% (0.1 mg/L) to 96.42% (1.0 mg/L), while, after 48 h, it ranged between 98 and 99% and reached 100% at the highest applied concentration.
Cadmium is recognized as a toxic metal for aquatic organisms, even at low concentrations. Studies such as the one conducted by Soininen et al. (2015) [41] have shown that cadmium exposure can cause acute and chronic effects on water fleas, including increased mortality and reduced reproductive capacity. Cadmium interferes with enzymatic functions and the energy metabolism of D. magna, significantly affecting development and life cycles [42]. Additionally, cadmium induces oxidative stress, leading to cellular damage and reducing the organisms’ ability to adapt to their environment.
Copper, on the other hand, is an essential nutrient with an important role in enzymatic processes and the physiological functioning of D. magna. In the studies conducted by Bossuyt and Janssen (2005) [43], low copper concentrations were associated with optimal metabolic function in water fleas. However, at high levels, copper becomes toxic and induces oxidative damage similar to that caused by cadmium, affecting fertility, swimming behavior, and growth rate in D. magna [44]. Unlike cadmium, copper can have positive effects at optimal concentrations, but it also becomes harmful when the tolerance threshold is exceeded.
The results obtained and presented in Figure 3 show that, in this study, cadmium was more toxic than zinc by 11–13%, depending on the concentrations to which the water fleas were exposed.
Comparatively, both metals, Cd2+ and Cu2+, exhibit significant negative effects on D. magna at high concentrations. However, copper, having an essential physiological role, can have positive effects at low concentrations, unlike cadmium, which is toxic even at lower levels.
Studies on the toxicity of metals such as zinc, copper, and cadmium on D. magna have shown variable mortality rates influenced by factors such as metal concentration and the age of the exposed organisms.
Traudt E. et al. (2017) [45] investigated the effect of age on the acute toxicity of cadmium, copper, nickel, and zinc in D. magna. Their results showed that younger neonates (0–4 h old) exhibited lower sensitivity to cadmium compared to older ones (20–24 h old), a finding that aligns with the results of this study.
Another study evaluated the interactive toxicity of nickel, zinc, copper, and cadmium on D. magna. It found that exposure to binary and quaternary metal combinations had variable effects on the survival and feeding behavior of the organisms, indicating complex interactions between these metals. Additionally, research has shown that exposure to copper and zinc can induce a range of toxic effects in D. magna, including impaired growth and reduced reproductive capacity [46,47].
After calculating the mortality rate of water fleas, the LC50 (Lethal Concentration 50%) was determined. This is a commonly used value in toxicology to determine the concentration of a chemical substance that causes the death of 50% of the tested organisms within a given timeframe. This measurement is critical for assessing the risks posed by various substances to ecological and human health. LC50 is used to establish the acute toxicity of chemical substances in aquatic, terrestrial, and aerial environments and can be determined for various organisms, such as fish, invertebrates, or aquatic plants [48].
The calculation of LC50 employs statistical methods such as probit analysis or the logarithmic method to estimate the midpoint of the dose–response curve. Results are often presented in a graph showing mortality as a function of substance concentration, with LC50 being the concentration corresponding to 50% mortality [49].
LC50 is essential in ecotoxicological studies for comparing the relative toxicity of different substances and estimating the risks of exposure to toxic substances in natural environments. Besides its application in aquatic environments, where it evaluates the effects of substances on fish and water fleas (D. magna), LC50 is also used in industries and medical research to determine safe exposure doses for workers and the general population [50]. Furthermore, LC50 values are included in chemical safety regulations, playing a crucial role in establishing permissible exposure limits.
Thus, LC50 is inversely proportional to toxicity: a substance with a low LC50 is more toxic than one with a higher LC50 [51].
To calculate the LC50 value, we applied the logarithmic method. The response of the D. magna population to the toxicity of heavy metals generated ascending sigmoidal curves, illustrated in Figure 4, which reflect the percentage mortality.
Figure 4.
Lethal concentration (LC50) of D. magna: (a) Zn2+ exposure; (b) Cu2+ exposure; (c) Cd2+ exposure.
The LC50 values obtained are presented in Table 2.
Table 2.
LC50 values for heavy metals used in experiments.
It can be observed that the lowest values (indicating the highest toxicity) are for Cd2+ and Cu2+ at the 24 h exposure interval, specifically 0.02 and 0.03, respectively.
It would be of great interest to explore how variations in pH and temperature influence the toxicity of cadmium, zinc, and copper to water fleas. Considering that these environmental parameters can affect both the solubility of metals and the physiological response of organisms, such investigations could provide a deeper understanding of the complex interactions between metals and environmental conditions [37]. Studying these effects could also contribute to the development of more effective strategies for managing metal pollution in aquatic ecosystems.
4. Conclusions
Following our investigation on the hatching of water fleas through exposure to heavy metals, we concluded that these metals influence the hatching rate of D. magna ephippia in various ways. Cadmium and copper tend to decrease the hatching rate as their concentrations increase, but the effect of cadmium proves to be stronger even at lower concentrations. In contrast, zinc has a more positive impact on hatching, stimulating the process, especially at the 42 h interval, with a hatching rate of between 80 and 90%. Additionally, zinc appears to have a reduced, less negative effect compared to cadmium and copper, even when its concentration increases, suggesting a higher tolerance of ephippia to this metal. Thus, zinc may have lower toxicity for D. magna than cadmium or copper at similar concentration intervals.
Regarding the exposure of newborn D. magna to the three heavy metals applied, it is notable that cadmium is the most toxic, even at low concentrations. Mortality increased significantly with the concentration and duration of exposure, with cadmium causing up to 100% mortality after 48 h. In comparison, zinc had lower toxicity, although the mortality rate increased substantially at higher concentrations and extended exposure periods. Copper, although toxic at high doses, can have beneficial effects in small amounts due to its physiological role in the organism. The LC50 values highlight the high risk of exposure to these metals even at moderate concentrations.
A study evaluating the toxic effects of copper sulfate on D. magna showed that an LC50 value of 4 mg/L after 24 h of exposure was lethal to 50% of neonates [52]. Another study investigated the influence of water hardness on zinc toxicity in D. magna. The results showed that, at a water hardness of 50 mg CaCO3/L, a zinc concentration of 50 µg/L resulted in 73% mortality after 96 h of exposure. In contrast, the same concentration of zinc in harder water did not cause significant mortality, highlighting the important role of water hardness in the bioavailability and toxicity of zinc [53].
It is important to note that LC50 values can vary significantly depending on factors such as water hardness, pH, temperature, and other environmental parameters. Therefore, interpreting these values must be conducted with caution, taking into account the specific conditions of each study.
Author Contributions
Conceptualization, P.C. and M.-C.P.; methodology, P.C.; software, G.B.; validation, P.C., M.-C.P., G.B. and C.C.; formal analysis, C.C.; investigation, P.C.; resources, P.C. and M.-C.P.; data curation, C.C.; writing—original draft preparation, P.C., M.-C.P., G.B. and C.C.; writing—review and editing, P.C. and M.-C.P.; visualization, C.C.; supervision, P.C. All authors have read and agreed to the published version of the manuscript.
Funding
This research received no external funding.
Data Availability Statement
The data generated during this study can be obtained upon request from the corresponding author.
Acknowledgments
The authors gratefully acknowledge the financial support provided by the Department of Land Improvement and Environmental Protection to Nicoleta Adriana Stan, which facilitated the execution of this research.
Conflicts of Interest
The authors declare no conflicts of interest.
References
- Ebert, D. Ecology, Epidemiology, and Evolution of Parasitism in Daphnia; National Center for Biotechnology Information (US): Bethesda, MD, USA, 2005; ISBN 1-932811-06-0. [Google Scholar]
- Lampert, W.; Sommer, U. Limnoecology: The Ecology of Lakes and Streams; Oxford University Press: Oxford, UK, 2007. [Google Scholar]
- Arao, T.; Kato, Y.; Nong, Q.D.; Yamamoto, H.; Watanabe, H.; Matsuura, T.; Tatarazako, N.; Tani, K.; Okamoto, A.; Matsumoto, T.; et al. Production of genome-edited Daphnia for heavy metal detection by fluorescence. Sci. Rep. 2020, 10, 21490. [Google Scholar] [CrossRef]
- Hooper, H.; Connon, R.; Callaghan, A.; Fryer, G.; Yarwood-Buchanan, S.; Biggs, J.; Maund, S.; Hutchinson, T.; Sibly, R. The ecological niche of Daphnia magna characterized using population growth rate. Ecology 2008, 89, 1015–1022. [Google Scholar] [CrossRef] [PubMed]
- Clare, J. Daphnia: An aquarist’s Guide. Caudata Online. 2002. Available online: www.caudata.org/daphnia (accessed on 22 April 2020).
- Coors, A.; Vanoverbeke, J.; De Bie, T.; De Meester, L. Land use, genetic diversity and toxicant tolerance in natural populations of Daphnia magna. Aquat. Toxicol. 2009, 95, 71–79. [Google Scholar] [CrossRef] [PubMed]
- Tiwari, A.; Dhanker, R.; Saxena, A.; Goyal, S.; Melchor-Martínez, E.M.; Iqbal, H.M.N.; Parra-Saldívar, R. Toxicity evaluation of personal care and household products as silent killers on survival of Daphnia magna. Case Stud. Chem. Environ. Eng. 2021, 4, 100124. [Google Scholar] [CrossRef]
- Seyoum, A.; Pradhan, A. Effect of phthalates on development, reproduction, fat metabolism and lifespan in Daphnia magna. Sci. Total Environ. 2019, 654, 969–977. [Google Scholar] [CrossRef]
- Czech, B.; Jośko, I.; Oleszczuk, P. Ecotoxicological evaluation of selected pharmaceuticals to Vibrio fischeri and Daphnia magna before and after photooxidation process. Ecotoxicol. Environ. Saf. 2014, 104, 247–253. [Google Scholar] [CrossRef] [PubMed]
- Valimaña-Traverso, J.; Amariei, G.; Boltes, K.; García, M.A.; Marina, M.L. Enantiomer stability and combined toxicity of duloxetine and econazole on Daphnia magna using real concentrations determined by capillary electrophoresis. Sci. Total Environ. 2019, 670, 770–778. [Google Scholar] [CrossRef]
- Canton, J.H.; Adema, D.M.M. Reproducibility of short-term and reproduction toxicity experiments with Daphnia magna and comparison of the sensitivity of Daphnia magna with Daphnia pulex and Daphnia cucullata in short-term experiments. Hydrobiologia 1978, 59, 135–140. [Google Scholar] [CrossRef]
- Steinkey, D.; Lari, E.; Woodman, S.G.; Luong, K.H.; Wong, C.S.; Pyle, G.G. Effects of gemfibrozil on the growth, reproduction, and energy stores of Daphnia magna in the presence of varying food concentrations. Chemosphere 2018, 192, 75–80. [Google Scholar] [CrossRef] [PubMed]
- Wan, M.T.; Watts, R.G.; Cheng, W. Acute Toxicity of Inorganic Chloramines to Daphnia magna in Two Types of Dilution Water. Bull. Environ. Contam. Toxicol. 2000, 65, 147–152. [Google Scholar] [CrossRef]
- Arienzo, M.; Albanese, S.; Lima, A.; Cannatelli, C.; Aliberti, F.; Cicotti, F.; Qi, S.; De Vivo, B. Assessment of the concentrations of polycyclic aromatic hydrocarbons and organochlorine pesticides in soils from the Sarno River basin, Italy, and ecotoxicological survey by Daphnia magna. Environ. Monit. Assess. 2015, 187, 52. [Google Scholar] [CrossRef] [PubMed]
- Nørgaard, K.B.; Cedergreen, N. Pesticide cocktails can interact synergistically on aquatic crustaceans. Environ. Sci. Pollut. Res. 2010, 17, 957–967. [Google Scholar] [CrossRef] [PubMed]
- He, F.; Wan, J.; Li, X.; Chu, S.; Sun, N.; Liu, R. Toxic effects of benzovindiflupyr, a new SDHI-type fungicide on earthworms (Eisenia fetida). Environ. Sci. Pollut. Res. 2021, 28, 62782–62795. [Google Scholar] [CrossRef] [PubMed]
- Nowakowski, K.; Sługocki, L. Short-term heat shock perturbation affects populations of Daphnia magna and Eurytemora carolleeae: A warning to the water thermal pollution. Sci. Rep. 2021, 11, 16909. [Google Scholar] [CrossRef]
- Margina, D.; Olaru, O.; Gutu, C.; Florea, L.; Gradinaru, D.; Purdel, C.; Ilie, M. Effects induced by natural extracts on Daphnia magna exposed to UV toxicity. Toxicol. Lett. 2015, 238, S286. [Google Scholar] [CrossRef]
- Zaldívar, J.M.; Baraibar, J. A biology-based dynamic approach for the reconciliation of acute and chronic toxicity tests: Application to Daphnia magna. Chemosphere 2011, 82, 1547–1555. [Google Scholar] [CrossRef]
- Rehman, A.; Chandio, A.A.; Hussain, I.; Jingdong, L. Fertilizer consumption, water availability and credit distribution: Major factors affecting agricultural productivity in Pakistan. J. Saudi Soc. Agric. Sci. 2020, 389, 122155. [Google Scholar] [CrossRef]
- Hare, L. Aquatic Insects and Trace Metals: Bioavailability, Bioaccumulation, and Toxicity. Crit. Rev. Toxicol. 1992, 22, 327–369. [Google Scholar] [CrossRef]
- Mebane, C.A.; Schmidt, T.S.; Miller, J.L.; Balistrieri, L.S. Bioaccumulation and Toxicity of Cadmium, Copper, Nickel, and Zinc and Their Mixtures to Aquatic Insect Communities. Environ. Toxicol. Chem. 2021, 40, 2374. [Google Scholar] [CrossRef]
- Cain, D.J.; Luoma, S.N.; Wallace, W.G. Linking metal bioaccumulation of aquatic insects to their distribution patterns in a mining-impacted river. Environ. Toxicol. Chem. 2004, 23, 1463–1473. [Google Scholar] [CrossRef]
- Closson, K.; Paul, E. Comparison of the toxicity of two chelated copper algaecides and copper sulfate to non-target fish. Bull. Environ. Contam. Toxicol. 2014, 93, 660–665. [Google Scholar] [CrossRef] [PubMed]
- Kang, L.; Mucci, M.; Fang, J.; Lürling, M. New is not always better: Toxicity of novel copper-based algaecides to Daphnia magna. Ecotoxicol. Environ. Saf. 2022, 241, 113817. [Google Scholar] [CrossRef]
- Fan, W.; Cui, M.; Liu, H.; Wang, C.; Shi, Z.; Tan, C.; Yang, X. Nano-TiO2 enhances the toxicity of copper in natural water to Daphnia magna. Environ. Pollut. 2011, 159, 729–734. [Google Scholar] [CrossRef] [PubMed]
- Gaetke, L.M.; Chow, C.K. Copper toxicity, oxidative stress, and antioxidant nutrients. Toxicology 2003, 189, 63–147. [Google Scholar] [CrossRef] [PubMed]
- Brix, K.V.; De Boeck, G.; Baken, S.; Fort, D.J. Adverse Outcome Pathways for Chronic Copper Toxicity to Fish and Amphibians. Environ. Toxicol. Chem. 2022, 41, 2911–2927. [Google Scholar] [CrossRef]
- Ishaque, A.B.; Johnson, L.; Gerald, T.; Boucaud, D.; Okoh, J. Assessment of Individual and Combined Toxicities of Four Non-Essential Metals (As, Cd, Hg and Pb) in the Microtox Assay. Int. J. Environ. Res. Public Health 2006, 3, 118–120. [Google Scholar] [CrossRef] [PubMed]
- Cañizares-Villanueva, R.O.; Martínez-Jerónimo, F.; Espinosa-Chávez, F. Acute toxicity to Daphnia magna of effluents containing Cd, Zn, and a mixture Cd-Zn, after metal removal by Chlorella vulgaris. Environ. Toxicol. 2000, 15, 160–164. [Google Scholar] [CrossRef]
- Li, M.; Tang, T.; Yuan, F.; Zhang, Y.; Li, F.; Liu, F. Protective effects of small heat shock proteins in Daphnia magna against heavy metal exposure. Sci. Total Environ. 2022, 848, 157565. [Google Scholar] [CrossRef]
- Livingstone, D.R. Contaminant-stimulated Reactive Oxygen Species Production and Oxidative Damage in Aquatic Organisms. Mar. Pollut. Bull. 2001, 42, 656–666. [Google Scholar] [CrossRef] [PubMed]
- Sanpradit, P.; Peerakietkhajorn, S. Disturbances in growth, oxidative stress, energy reserves and the expressions of related genes in Daphnia magna after exposure to ZnO under thermal stress. Sci. Total Environ. 2023, 869, 161682. [Google Scholar] [CrossRef]
- De Schamphelaere, K.A.C.; Canli, M.; Van Lierde, V.; Forrez, I.; Vanhaecke, F.; Janssen, C.R. Reproductive toxicity of dietary zinc to Daphnia magna. Aquat. Toxicol. 2004, 70, 233–244. [Google Scholar] [CrossRef]
- Vandenbroucke, A.M.; Morent, R.; De Geyter, N.; Leys, C. Non-thermal plasmas for non-catalytic and catalytic VOC abatement. J. Hazard. Mater. 2011, 195, 30–54. [Google Scholar] [CrossRef] [PubMed]
- Muyssen, B.T.A.; Messiaen, M.; Janssen, C.R. Combined cadmium and temperature acclimation in Daphnia magna: Physiological and sub-cellular effects. Ecotoxicol. Environ. Saf. 2010, 73, 735–742. [Google Scholar] [CrossRef] [PubMed]
- Heugens, E.H.W.; Jager, T.; Creyghton, R.; Kraak, M.H.S.; Hendriks, A.J.; Van Straalen, N.M.; Admiraal, W. Temperature-Dependent Effects of Cadmium on Daphnia magna: Accumulation versus Sensitivity. Environ. Sci. Technol. 2003, 37, 2145–2151. [Google Scholar] [CrossRef]
- OECD Guidelines for the Testing of Chemicals, Section 2. 2004, Test no. 202: Daphnia sp. Acute Imobilisation Test. Available online: https://doi.org/10.1787/9789264069947-en (accessed on 23 November 2024).
- Barata, C.; Baird, D.J.; Soares, A.M.V.M. Demographic responses of a tropical cladoceran to cadmium: Effects of food supply and density. Ecol. Appl. 2002, 12, 552–564. [Google Scholar] [CrossRef]
- Muyssen, B.T.A.; De Schamphelaere, K.A.C.; Janssen, C.R. Mechanisms of chronic waterborne Zn toxicity in Daphnia magna. Aquat. Toxicol. 2006, 77, 393–401. [Google Scholar] [CrossRef]
- Soininen, J.; Bartels, P.; Heino, J.; Luoto, M.; Hillebrand, H. Towards more integrated ecosystem research in aquatic and terrestrial environments. Environ. Pollut. 2015, 202, 6–10. [Google Scholar] [CrossRef]
- Baudouin, M.F.; Scoppa, P. The toxic effects of cadmium on Daphnia magna. Environ. Res. 1974, 7, 95–101. [Google Scholar]
- Bossuyt, B.T.A.; Janssen, C.R. Copper toxicity to different field-collected cladoceran species: Intra- and inter-species sensitivity. Environ. Pollut. 2005, 136, 145–154. [Google Scholar] [CrossRef] [PubMed]
- Bodar, C.W.; Hendriks, A.J.; Sijm, D.T. Chronic toxicity of copper and cadmium to Daphnia magna: Effect of exposure time on sensitivity. Ecotoxicol. Environ. Saf. 1988, 15, 72–78. [Google Scholar]
- Traudt, E.M.; Ranville, J.F.; Meyer, J.S. Effect of age on acute toxicity of cadmium, copper, nickel, and zinc in individual-metal exposures to Daphnia magna neonates, Environ. Toxicol. Chem. 2017, 36, 113–119. [Google Scholar] [CrossRef]
- Lari, E.; Gauthier, P.; Mohaddes, E.; Pyle, G. Interactive toxicity of Ni, Zn, Cu, and Cd on Daphnia magna at lethal and sub-lethal concentrations. J Hazard Mater. 2017, 334, 21–28. [Google Scholar] [CrossRef] [PubMed]
- Paylar, B.; Bezabhe, Y.H.; Jass, J.; Olsson, P.-E. Exploring the Sublethal Impacts of Cu and Zn on Daphnia magna: A transcriptomic perspective. BMC Genom. 2024, 25, 790. [Google Scholar] [CrossRef]
- Rand, G.M. Fundamentals of Aquatic Toxicology: Effects, Environmental Fate and Risk Assessment; Taylor & Francis: Abingdon, UK, 1995. [Google Scholar]
- Sprague, J.B. The ABCs of pollutant bioassay using fish. In Biological Methods for the Assessment of Water Quality; ASTM International: West Conshohocken, PA, USA, 1973. [Google Scholar]
- Newman, M.C.; Clements, W.H. Ecotoxicology: A Comprehensive Treatment; CRC Press: Boca Raton, FL, USA, 2008. [Google Scholar]
- AAT Bioquest, Inc. Quest GraphTM LC50 Calculator. 2024. Available online: https://www.aatbio.com/tools/lc50-calculator (accessed on 20 November 2024).
- Rajaretnam, A.S.; Stanley, S.A. Studies on the toxicological effects of bimetals on the cladoceran, Daphnia magna and examination of histopathological effects through Transmission Electron Microscopy (TEM). J. Chem. Pharm. Res. 2015, 7, 506–511. [Google Scholar]
- Paylar, B.; Asnake, S.; Sjöberg, V.; Ragnvaldsson, D.; Jass, J.; Olsson, P.-E. Influence of water hardness on zinc toxicity in Daphnia magna. J. Appl. Toxicol. 2022, 42, 1510–1523. [Google Scholar] [CrossRef] [PubMed]
Disclaimer/Publisher’s Note: The statements, opinions and data contained in all publications are solely those of the individual author(s) and contributor(s) and not of MDPI and/or the editor(s). MDPI and/or the editor(s) disclaim responsibility for any injury to people or property resulting from any ideas, methods, instructions or products referred to in the content. |
© 2025 by the authors. Licensee MDPI, Basel, Switzerland. This article is an open access article distributed under the terms and conditions of the Creative Commons Attribution (CC BY) license (https://creativecommons.org/licenses/by/4.0/).